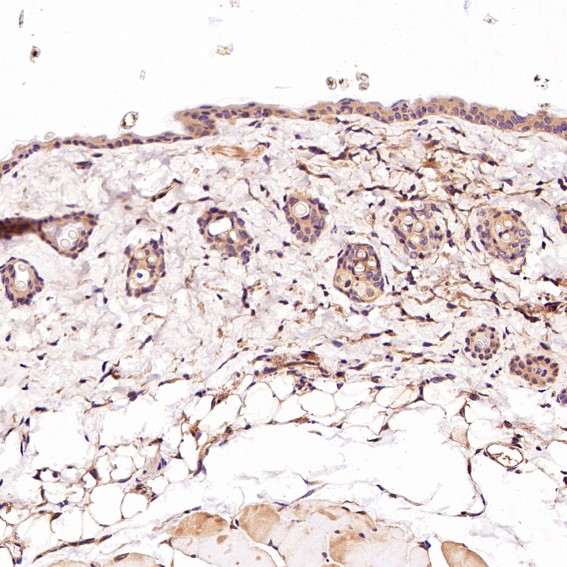

| Western blot (WB): | 1:500-2000 |
| Immunohistochemistry (IHC): | 1:50-200 |
| Immunocytochemistry/Immunofluorescence (ICC/IF): | 1:50-200 |
| Flow Cytometry (FCM): | 1:20 |

Western blot analysis of CD45 expression in Jurkat cell lysate.

Immunohistochemical analysis of paraffin-embedded Rat stomach, using the Antibody.

Immunohistochemical analysis of paraffin-embedded Mouse skin, using the Antibody.

Immunohistochemical analysis of paraffin-embedded Mouse lung, using the Antibody.

Immunohistochemical analysis of paraffin-embedded human spleen, using CD45 Antibody .

Immunohistochemical analysis of paraffin-embedded Human placenta, using the Antibody.

Western blot analysis of CD45 expression in Jurkat cell lysate.

Immunohistochemical analysis of paraffin-embedded Rat stomach, using the Antibody.

Immunohistochemical analysis of paraffin-embedded Mouse skin, using the Antibody.

Immunohistochemical analysis of paraffin-embedded Mouse lung, using the Antibody.

Immunohistochemical analysis of paraffin-embedded human spleen, using CD45 Antibody .

Immunohistochemical analysis of paraffin-embedded Human placenta, using the Antibody.